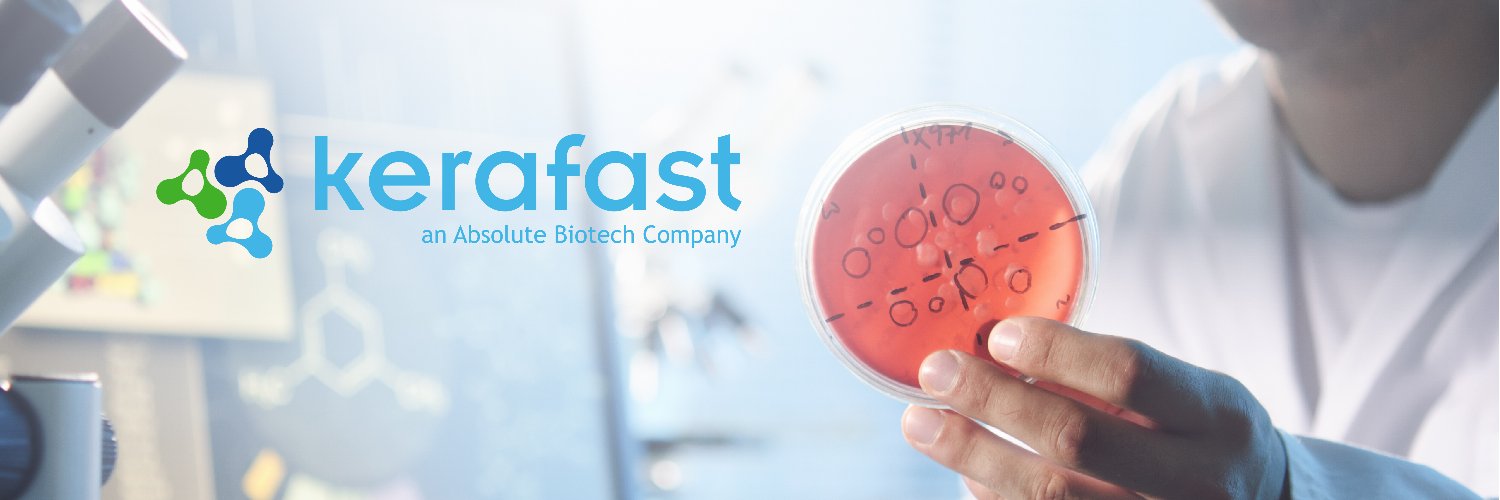
Kerafast banner

Sabitlenmiş Tweet

Starting April 2023, this page won't be active anymore. To avoid missing out on all things Kerafast, stay informed on the latest breakthroughs in antibody research from our parent company, @AbsoluteBiotech.

English
Kerafast
1.9K posts

@kerafast
Kerafast facilitates access to unique bioresearch materials from prominent institutions around the world. Part of @AbsoluteBiotech.
































